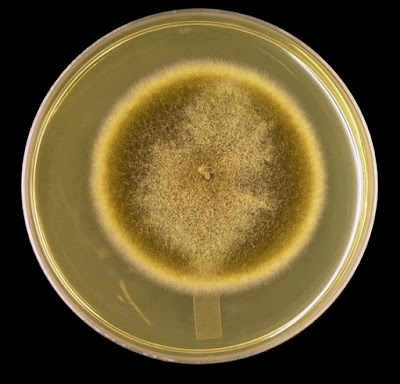

Stemphylium species(Hyphomycetes)
Ecology:
Stemphylium species are widely distributed in nature and can be found in soils as well as plant parasites and as saprophytes on decaying plant material. As a plant pathogen, Stemphylium species are implicated in the leaf spot of alfalfa (S.botryosum), black rot of carrots (S.radicinum), and grey leaf spot of the tomato plant (S.solani).
Pathogenicity:
Stemphyliumspecies found in the clinical laboratory are generally considered to be contaminants; however, they may contribute to allergic reactions in general and have been reported as agents of phaeohyphomycotic sinusitis.
Macroscopic Morphology:
Colonies on SAB are velvety to cottony with a rather short ‘nap’ (does not extend very high above the agar surface). They are olivaceous (grey-green-brown) to a brownish-black in surface colour. The reverse is black. Stemphylium species exhibit a moderate growth rate, becoming mature within five days.
Microscopic Morphology:
Hyphae are septate and develop a pale brown to deeper brownish colour as they age. Conidiophores also show septations and the structure is simple or occasionally branched. The cell at the apex of the conidiophore which bears the conidium may show a slight swelling in relation to the rest of the conidiophore. The conidiophore which generally shows somewhat smooth and parallel walls when young may develop a much more knobby appearance as it ages and produces conidia. Conidia (12 – 20 µm X 15 – 30 µm) are produced by growing from the tip of the terminal conidiogenous cell (poroconidia). They can be smooth or rough (echinulate) in texture. They have been described as oval, oblong, ellipsoidal, obclavate and subspherical. More simply they may be described as ‘box-like’ with rounded corners. The conidia may also show a marked constriction around a central septum or division within individual conidia. The conidia are muriform (both transverse and longitudinal septations or divisions), and acquire a dark brown pigment as they mature.
Caution: Micron scale (µm) may change between 50 or 100 µm at higher magnifications.
Caution: Micron scale (µm) may change between 50 or 100 µm at higher magnifications.
Stemphylium species - not much to distinguish between other moulds in this photo. I've added it just to show the tangled mass of the mycelium that fungi produce. Conidia are visible as the dark spots but features are indistinguishable at this magnification.
(250X, LPCB, DMD-108)
Stemphylium species - edge of a slide culture showing hyphae growing out from the edge of the SAB block from which conidiophores extend and produce pigmented conidia at the ends.
(250X, LPCB, DMD-108)
Stemphylium species -another shot showing numerous pigmented conidia sitting on the ends of the conidiophores which extend at right-angles from the supporting vegetative hyphae.
(250X, LPCB, DMD-108)
Stemphylium species -more detail emerges at this higher magnification. Septations become visible in the pigmented conidia.
(400X, LPCB, DMD-108)
Stemphylium species -hyphae and conidiophores.
(400+10X, LPCB, DMD-108)
Stemphylium species -rather short conidiophores, extend primarily at right-angles from the parent vegetative hypha. At the lower left corner there is a branched conidiophore with a rather young, still unpigmented, conidium developing on the left branch. Two more young conidia can be seen in the photo as well.
(400X, LPCB, DMD-108)
Stemphylium species -a few more photos to leave you with an impression of what Stemphylium looks like. Conidia can be longer and branched which distinguishes it from Pithomyces species. The shape of the conida also is different from Pithomyces - discussed in later photos.
(400X, LPCB, DMD-108)
Stemphylium species -brown pigmented conidia at the apices of individual conidiophores extending from an 'out of focus' hyphal element.
(400X, LPCB, DMD-108)
Stemphylium species -conidiophores extending from the supporting vegetative hyphae with conidia at various stages of maturity. Young, blue-stained conidia and brown pigmented mature conidia are present. (400X, LPCB, DMD-108)
Stemphylium species -ditto.
(400X, LPCB, DMD-108)
Stemphylium species -self indulgence here. More photos to demonstrate the same, Conidiophores with mature pigmented conidia at the tips. Muriform (longitudinal & transverse) septation is apparent. (400X, LPCB, DMD-108)
Stemphylium species -the appearance in this photo is very similar to that of Pithomyces species in that there are conidia at the ends of short conidiophores arising at right-angles to the hyphae from which they extend. Darkly pigmented conidia have internal compartments made by the muriform (both up and down and across) septations. The pigmented hyphae to the left of the photo is clearly septate and appears to be releasing it's pigment into the medium (brown haze).
(400X, LPCB, DMD-108)
Stemphylium species -as above.
Stemphylium species -massive amounts of conidia can be produced as seen here.
(400X, LPCB, DMD-108)
Stemphylium species - a slightly closer look. Muriform septations evident in the mature brown conidia. The shape has been described as oval, oblong, ellipsoidal, obclavate and subspherical. More simply they may be described as ‘box-like’ with rounded corners.
(400+10X, LPCB, DMD-108)
Stemphylium species - The conidiophore which generally shows somewhat smooth and parallel walls when young may develop a much more knobby appearance as it ages and produces conidia (lower left). (400+10X, LPCB, DMD-108)
Stemphylium species - mature brown box-like conidia at the ends of somewhat knobby conidiophores. (400+10X, LPCB, DMD-108)
Stemphylium species - conidia with muriform septations.
(400+10X, LPCB, DMD-108)
Stemphylium species - ditto, as above.
(400+10X, LPCB, DMD-108)
Stemphylium species -the conidia may also show a marked constriction around a central septum or division within individual conidia (arrows).
(400+10X, LPCB, DMD-108)
Stemphylium species - conidia (12 – 20 µm X 15 – 30 µm, when mature) are produced by growing from the tip (arrow) of the terminal conidiogenous cell (poroconidia).
(1000X, LPCB, DMD-108)
Stemphylium species - here on another conidiophore you can see the conidium (poroconidium) increasing in size as it develops. Internal septations have yet to develop.
(1000X, LPCB, DMD-108)
Stemphylium species - branching conidiophore -mature brown conidia and a smaller and younger, pale blue conidium. To follow along from the last two photos, the pale blue conidium is developing further and starting to develop a transverse septum (light line crossing the inside of the small blue conidium). (400+10X, LPCB, DMD-108)
Stemphylium species - Mature brown muriform septate conidia showing central construction along where the transverse septum crosses. Conidiophores may develop a knobby appearance with maturity and the cell at the apex of the conidiophore which bears the conidium may show a slight swelling in relation to the rest of the conidiophore.
(1000X, LPCB, DMD-108)
Stemphylium species - as above.
(1000X, LPCB, DMD-108)
Stemphylium species - As above. Different stages of maturity. Too many photos, I know!
(1000X, LPCB, DMD-108)
Stemphylium species - ditto.
(1000X, LPCB, DMD-108)
Stemphylium species - conidia can be smooth or rough (echinulate) in texture.
(1000+10X, LPCB, DMD-108)
Stemphylium species - can be smooth or rough (echinulate) in texture. Conidiogenous cell at tip of conidiophore may be somewhat distended (wider, swollen) in relation to the rest of the conidiophore.
(1000+10X, LPCB, DMD-108)
Stemphylium species - conidiophore shows septation.
(1000+10X, LPCB, DMD-108)
Stemphylium species - again, conidiogenous cell closest to the tip may show a slight swelling in relation to the rest of the conidiophore.
(1000+10X, LPCB, DMD-108)
Stemphylium species - conidia with various surface textures.
(1000+10X, LPCB, DMD-108)
Stemphylium species - yet another photo! You get the picture by now...
(1000+10X, LPCB, DMD-108)
Stemphylium species
(1000+10X, LPCB, DMD-108)
Stemphylium species
Stemphylium species - poroconidium (doesn't show the annular frill which is seen on somewhat similar looking muriform conidia produced by Pithomyces species.
(1000+10X, LPCB, DMD-108)
Stemphylium species - looks like a degenerating, rather wilted conidiophore.
(1000+10X, LPCB, DMD-108)
Stemphylium species- branching septate conidiophore.
(1000+10X, LPCB, DMD-108)
Stemphylium species - branching conidiophore.
(1000+10X, LPCB, DMD-108)
Stemphylium species
(1000+10X, LPCB, DMD-108)
Stemphylium species
(1000+10X, LPCB, DMD-108)
Stemphylium species
(1000+10X, LPCB, DMD-108)
Stemphylium species
(1000+10X, LPCB, DMD-108)
Stemphylium species -Last one. I don't know what I was thinking, uploading some 45 photos to illustrate Stemphylium species. As with most of the posts in this blog, the photos posted represent only 10% of what I've taken. Sorry for anyone who I lost with boredom -I find the little critters fascinating.
(1000+10X, LPCB, DMD-108)
Note: May be confused with other darkly pigmented moulds such as Alternaria species,Pithomyces species, and Ulocladium species (see table below).
Too small to read? Click on table to get image. Now right click on image and select 'view image'. In Windows, cursor now has a + sign within it. Click on image of table to now magnify the table.
Alternatively, just click and download the damn thing...
* * *
Alternatively, just click and download the damn thing...
* * *